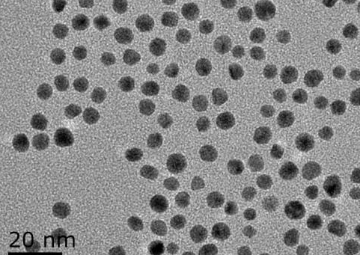
image.png

油无水磷酸氢球型金nm粉末,颗粒直径5nm
【商命名称】圆形金奈米顆粒
【国外英文简称】Au nanoparticles
【粒度分布】5nm
【组成】金納米颗粒肥料、净水、柠檬百香果酸钠
【性 状】金纳米颗粒的水溶液随粒径不同呈现橙红、红、紫红等颜色。
【应用场景】海洋生物免疫性加测、球蛋白箭头、暗场光电器件影像、荧光资料学习、面上资料学习拉曼肌底、物承载等
【特 点】金纳米颗粒表面带负电荷,根据需要可以调制表面电荷 高比表面积,高负载量,易于表面功能化|消减性、增强性佳保存期期:6六个月(4度保护)
彩石納米颗粒状是尽寸在1-100nm的废金屬分子聚团队,比光的光波波长还小。而致宽度小,会产生了量子限域相互作用,不断增加或避免废金屬分子生长率会导致其结构设计、电子技术和磁学概念的**发生变化。于是,与宏观环境废金屬用料有所差异,废金屬nm顆粒的宽度、形貌相应营养元素分散选择其运动学情形、面吸附物、运载、催化剂的作用亲水性和光电产品概念。
成都pg电子娱乐游戏app
生物学让各位大家能展示 4种区别核壳型的荧光量子包扩有:CdSe/ZnS硒化镉-加硫锌量子点 ,CdS/ZnS加硫镉-加硫锌荧光量子点,InP/ZnS磷化处理铟-加硫锌荧光量子点,ZnSe/ZnS硒化锌-加硫锌荧光量子点三种。还让各位大家还展示 区别外表配体的核壳型荧光量子点类成品的包扩有:十九胺、alkyl、油酸、氨基和羧基。让各位大家的Fluorescent nanocrystals类成品的还包扩脂可溶的和水可溶的,水可溶的是可以通过外面包含四层聚乙二醇PEG而实现了水可溶的,外表能体现氨基和羧基。订做类成品的:近红外 PbS 量子点水无水磷酸氢近红外 PbS 量子点 -发射成功峰位置上 1300±50 nm水无水磷酸氢近红外 PbS 量子点 -射峰具体位置 1300±50 nm水无水磷酸氢近红外 PbS 量子点 -放射峰方位 1200±50 nm水无水磷酸氢近红外 PbS 量子点 -射出峰部位 1200±50 nm水可溶近红外 PbS 量子点 -发送峰位子 1100±50 nm水阴离子型近红外 PbS 量子点 -导弹峰位址 1100±50 nm水溶解性近红外 PbS 量子点 -发送峰座位 900±50 nm水可溶性近红外 PbS 量子点 -射峰地理位置 1000±50 nm水溶解性近红外 PbS 量子点 -卫星发射峰地位 1000±50 nm水可溶性近红外 PbS 量子点 -射出峰地段 900±50 nm水无水磷酸氢近红外 PbS 量子点 -试射峰地理位置 900±50 nm近红外量子点重要有接下来多种:
色度:99%
制造地:武汉
的主要用途是什么:仅主要用于科研课题(zyl2022.04.25)